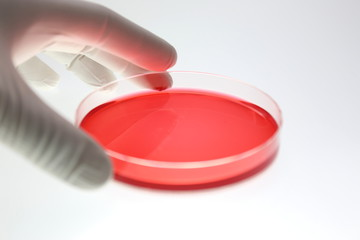

再生医療 豆知識
再生医療に関する様々な豆知識をご紹介します。

今様々な分野で話題の再生医療ですが、そもそも幹細胞ってなに??といった基本的な疑問から、どんなことに再生医療は応用されているの?といった疑問まで解決できるような豆知識を皆様にご紹介するページです。再生医療に関して少しでも身近に感じていただけると幸いです。
幹細胞って何だろう??

私たちの体のはじまりは受精卵という一つの細胞でした。一つの受精卵が分裂していくことで私たちの体の組織や器官は出来上がります。
つまり受精卵のように、まだどの機能を持つ細胞かに分かれていない状態の細胞=未分化の細胞を「幹細胞」と言います。幹細胞の働きの一つに分化があります。幹細胞は分裂することにより皮膚や骨、血液や筋肉に分かれていきます。その働きにより私たち人間は受精卵という一つの細胞からさまざまな器官や能力をもつ体へと分裂していくことができます。つぎに複製という働きがあります。幹細胞はそれ自身と全く同じ細胞に分裂することができます。それにより私たちは成長することや、ケガや病気になった時に自分自身で傷ついた細胞を修復したり再生することができます。
PRP(多血小板血漿)ってどんな働きがあるの?

血液から分離したPRP(多血小板血漿)
PRPとは、Platelet Rich Plasma(多血小板血漿)のことで、血液中で血小板をより多く含む血漿成分です。最新の研究から血小板には組織を再生させるための様々なサイトカインが含まれており、傷を治したり、お肌のエイジングケア、美肌効果を促したりすることができることが分かってきました。
再生医療でできることって何だろう?
再生医療とは、病気やケガにより失われてしまった体の様々な機能を再び回復させることを目的にした医療です。例えば幹細胞の持つ様々な細胞に分化する働きや、自らの細胞を複製する働きを活用して今まで完治の難しかった病気の治療が可能になる可能性があります。最近では脊椎損傷の再生医療の認可について大きなニュースになりました。正式に認可されることになれば、治療の対象にも制限はありますが根本治療の難しかった現在の医療に対して大きな進歩となり、患者さまにとって大きな希望となります。このように今まで根治の難しかった難病に対しての治療に大きな可能性が再生医療にはあります。
幹細胞治療ってなに?幹細胞コスメとの違いは?

幹細胞コスメは幹細胞培養上清液を使用した美容液で表皮からのアプローチであるのに対し、幹細胞治療はご自分の肌細胞(線維芽細胞)を抽出・培養したものを直に肌内部に注入することでお肌を再生させる肌再生医療のひとつです。また、若い時の細胞を冷凍保存・再移植できるのも幹細胞治療だけの特徴と言えます。
フォーシーズンズオリジナルのメンテナンス1幹細胞美容液は医師監修の再生医療のメカニズムに基づいた効果が期待できる製品です。
再生医療のホームケアとして使用されると効果の持続力アップなどの相乗効果が期待できます。
どのくらい皮膚が必要なの?
なぜ耳の裏なの?

幹細胞治療において必要な皮膚は米粒大です。皮膚の採取は通常耳の裏から行います。なぜなら耳の後ろの肌細胞は、紫外線などの外部刺激も少なく、お顔周りの中でも比較的元気な肌細胞が採取できるからです。
さらに耳の裏のため切開した傷は目立ちにくく、施術後傷跡を気にすることなく外出して頂けます。施術には麻酔も行いますので、痛みに弱い方もご安心下さい。
細胞はどこで培養・保管されるの?

採取した皮膚と血液は、提携している再生医療支援会社の細胞培養センター(特定細胞加工物製造事業者)に搬送されます。
そこで肌細胞の抽出と抽出した肌細胞を約10,000倍に培養いたします。(1cc辺り1億個以上)増殖培養にはおよそ5週間程度かかりますので、 皮膚採取から5週間以上あけて、次回のご予約をお取りください。
また、採取した皮膚から、肌細胞(真皮線維芽細胞)の種となる「幹細胞」を60本程度保管しておくこともできます。元気な状態の細胞を保存することが可能なため、何年経っても移植したい時にいつでも、保存しておいた細胞を肌に移植することが可能です。
もっと再生医療について知りたい方は

再生医療に関して興味を持っていただきありがとうござます。
もっと再生医療について知りたいという方は、無料カウンセリングをご予約下さい。様々な疑問にお答えすることができます。お気軽にご相談ください。皆様のご来院をこころよりお待ちしております。
クリニック概要
当院の認可(厚生労働省受理)

再生医療第二種
自家培養真皮繊維芽細胞移植術
再生医療第三種
PRP(多血小板血漿Platelet Rich Plasma)を用いた皮膚の再生を目的とした再生医療
再生医療第三種
PRP(多血小板血漿Platelet Rich Plasma)を用いた育毛を目的とした再生医療
一、二、三次救急時 連携指定病院
- 明和病院
